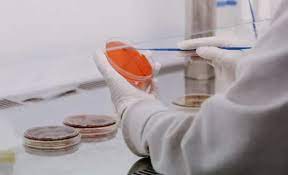

State of play 2025: les novetats de jocs de la PlayStation
Dimecres dia 12 de febrer es va emetre en directe un State of play (acte on es fan els anuncis de PlayStation). En aquest acte es van donar molts jocs i les seves dates de sortida respectivament. Els jocs que van sortir van ser: Saros, Metal Gear Solid Delta: Snake Eater, Borderlands 4, Onimusha (Remake […]
State of play 2025: les novetats de jocs de la PlayStation Llegeix més »